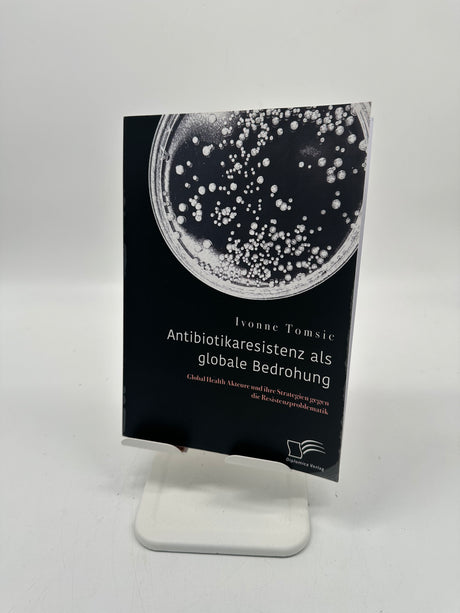

🪑 ALEOS. Hängesessel Beige mit Kissen
33,50 €49,99 €Grundpreis /Nicht verfügbarSehr geringer Bestand (1 Einheit)🤰 Alle Babys schlafen schon – Vorlesebuch mit Traum-Tagebuch (paperu)
9,99 €14,95 €Grundpreis /Nicht verfügbarSehr geringer Bestand (1 Einheit)🛞 Alligator Ventileinziehhebel 2-in-1
13,40 €19,85 €Grundpreis /Nicht verfügbarSehr geringer Bestand (1 Einheit)📅 Almanach 2025 – Rätsel · Spiele · Weisheiten
20,93 €29,90 €Grundpreis /Nicht verfügbarSehr geringer Bestand (6 Einheiten)🌟 Almina Islamische Gebetsteppich – 80 x 120 cm, B-Ware 🌟
9,00 €19,95 €Grundpreis /Nicht verfügbarSehr geringer Bestand (1 Einheit)📄 Amazon Basics Druckerpapier A4 – 500 Blatt
2,90 €4,75 €Grundpreis /Nicht verfügbarAuf Lager (23 Einheiten)🧲 Andy Warhol Soup Can Magnet-Set
6,70 €9,20 €Grundpreis /Nicht verfügbarAuf Lager (51 Einheiten)🧠 Angst, Schmerz, Wut, Ohnmacht (Christian Meyer)
9,99 €19,90 €Grundpreis /Nicht verfügbarSehr geringer Bestand (1 Einheit)🎵 Anna Butterss – Mighty Vertebrate (Vinyl, Jazz/Blues)
18,75 €27,99 €Grundpreis /Nicht verfügbarSehr geringer Bestand (1 Einheit)- 27,99 €
39,99 €Grundpreis /Nicht verfügbarSehr geringer Bestand (1 Einheit) 🧺 ANTOWIN Schubladentrenner Bambus – B-Ware!
10,05 €15,25 €Grundpreis /Nicht verfügbarSehr geringer Bestand (1 Einheit)🎨 Aquarellpapier A3 – 50 Blatt
16,75 €24,99 €Grundpreis /Nicht verfügbarSehr geringer Bestand (7 Einheiten)🧴 Aquasonic Clear Ultraschallgel 5L
36,85 €54,99 €Grundpreis /Nicht verfügbarSehr geringer Bestand (1 Einheit)🚗 ARAL Super Tronic K 5W-30 1L
6,00 €14,95 €Grundpreis /Nicht verfügbarSehr geringer Bestand (1 Einheit)🔧 ARLI Revisionsschacht 200x200x200 mm – B-Ware!
8,99 €16,99 €Grundpreis /Nicht verfügbarSehr geringer Bestand (1 Einheit)

Über uns
Wir sind Maschinenbau Hanstein, ein familiengeführtes Unternehmen, das sich der Bereitstellung hochwertiger Ersatzteile und erstklassiger Dienstleistungen widmet. Unter der Leitung von André und Tanja Hanstein streben wir danach, den Arbeitsalltag unserer Kunden durch langlebige und zuverlässige Lösungen zu optimieren.